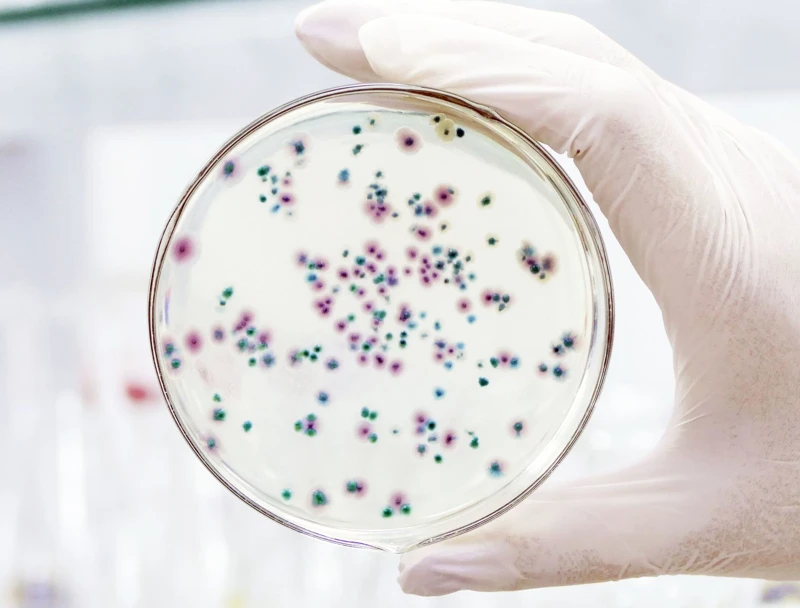
Kiểm soát hiệu quả khuẩn hại Vibrio Para trong ao nuôi tôm bằng AmBio và AnTi Vib

- VI
- EN
0
0

🚨 Phân trắng – căn bệnh quen mà “khó chịu” bậc nhất trong ao nuôi tôm! Bạn đã từng đau đầu vì tôm: ❌ Ăn yếu – phân đứt khúc – ruột mờ ❌ Thả 20 ngày là dính bệnh ❌ Trị xong... lại tái phát?

GanT và AmBio Liver là hai sản phẩm hỗ trợ gan tụy được nhiều người nuôi tôm tin dùng. 2 sản phẩm có điểm giống và khác nhau. Nếu sử dụng đúng cách, chúng sẽ giúp cải thiện sức khỏe gan tụy, tăng sức đề kháng và hỗ trợ tiêu hóa cho tôm. Dưới đây là những điểm và khác nhau, lợi ích khi dùng hai sản phẩm này trong quá trình nuôi



Vai trò thiết yếu của xử lý đáy ao nuôi tôm: Đáy ao là nơi diễn ra nhiều hoạt động sinh học quan trọng ảnh hưởng trực tiếp đến sức khỏe và sự phát triển của tôm.